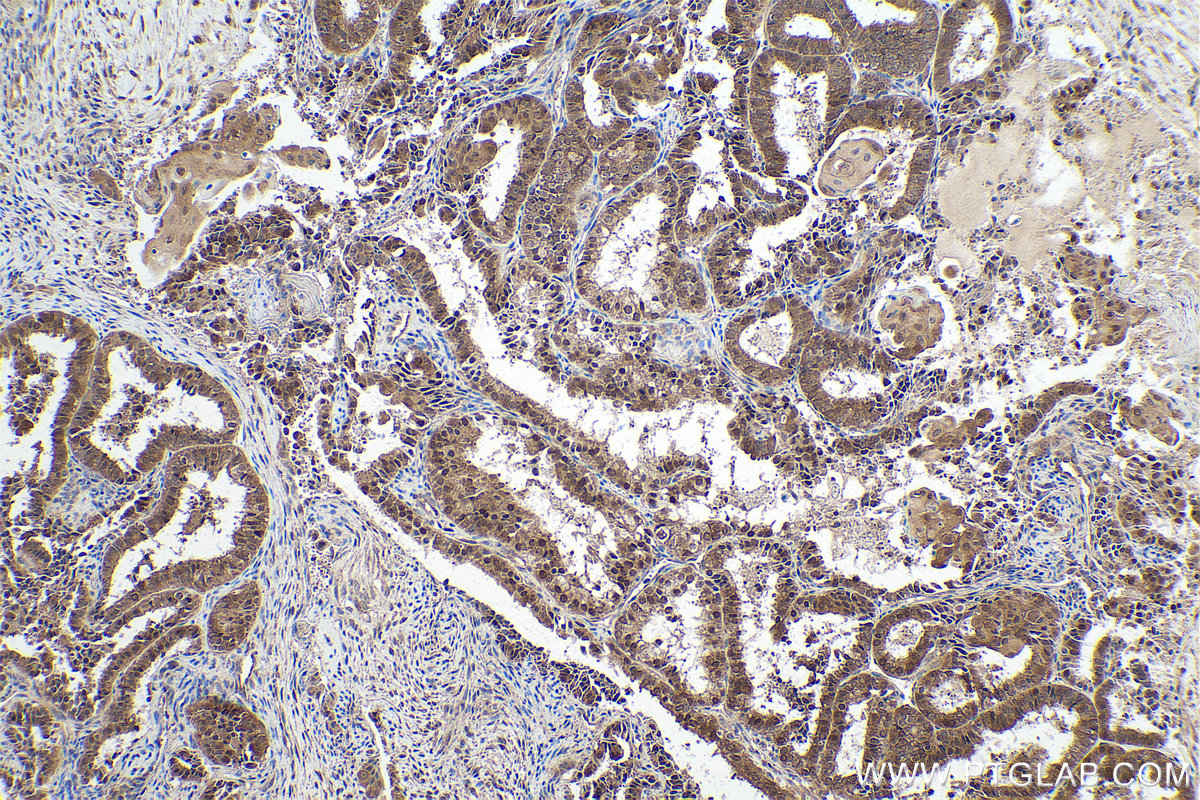

验证数据展示
经过测试的应用
| Positive WB detected in | human brain tissue, NIH/3T3 |
| Positive IP detected in | mouse brain tissue |
| Positive IHC detected in | human cervical cancer tissue, human ovary tumor tissue, mouse colon tissue Note: suggested antigen retrieval with TE buffer pH 9.0; (*) Alternatively, antigen retrieval may be performed with citrate buffer pH 6.0 |
推荐稀释比
| 应用 | 推荐稀释比 |
|---|---|
| Western Blot (WB) | WB : 1:500-1:2000 |
| Immunoprecipitation (IP) | IP : 0.5-4.0 ug for 1.0-3.0 mg of total protein lysate |
| Immunohistochemistry (IHC) | IHC : 1:250-1:1000 |
| It is recommended that this reagent should be titrated in each testing system to obtain optimal results. | |
| Sample-dependent, Check data in validation data gallery. | |
产品信息
10140-2-AP targets PPP1CB in WB, IHC, IF, IP, ELISA applications and shows reactivity with human, mouse, rat samples.
| 经测试应用 | WB, IHC, IP, ELISA Application Description |
| 文献引用应用 | WB, IHC, IF, IP |
| 经测试反应性 | human, mouse, rat |
| 文献引用反应性 | human, mouse, rat |
| 免疫原 |
CatNo: Ag0183 Product name: Recombinant human PPP1CB protein Source: e coli.-derived, PGEX-4T Tag: GST Domain: 1-183 aa of BC002697 Sequence: MADGELNVDSLITRLLEVRGCRPGKIVQMTEAEVRGLCIKSREIFLSQPILLELEAPLKICGDIHGQYTDLLRLFEYGGFPPEANYLFLGDYVDRGKQSLETICLLLAYKIKYPENFFLLRGNHECASINRIYGFYDECKRRFNIKLWKTFTDCFNCLPIAAIVDEKIFCCHGGLSPDLQSME 种属同源性预测 |
| 宿主/亚型 | Rabbit / IgG |
| 抗体类别 | Polyclonal |
| 产品类型 | Antibody |
| 全称 | protein phosphatase 1, catalytic subunit, beta isoform |
| 别名 | Serine/threonine-protein phosphatase PP1-beta catalytic subunit, PPP1CD, PP-1B, PP1 Beta, PP 1B |
| 计算分子量 | 37 kDa |
| 观测分子量 | 37 kDa |
| GenBank蛋白编号 | BC002697 |
| 基因名称 | PPP1CB |
| Gene ID (NCBI) | 5500 |
| RRID | AB_2168272 |
| 偶联类型 | Unconjugated |
| 形式 | Liquid |
| 纯化方式 | Antigen affinity purification |
| UNIPROT ID | P62140 |
| 储存缓冲液 | PBS with 0.02% sodium azide and 50% glycerol, pH 7.3. |
| 储存条件 | Store at -20°C. Stable for one year after shipment. Aliquoting is unnecessary for -20oC storage. |
背景介绍
Protein phosphatase 1 (PP1) is the main eukaryotic protein serine/threonine phosphatase that regulates an enormous variety of cellular processes including protein-protein interactions, gene transcription, cell-cycle progression and apoptosis. It is a trimeric complex composed of a regulatory subunit, a variable subunit and a catalytic subunit. The catalytic subunit of PP1 (PP1c) can interact with amount of regulatory subunits in vivo that target it to particular subcellular locations and regulate its activity towards specific substrates. PPP1CB migrated as a 37kd protein on SDS page. This antibody is specific to PPP1CB.
实验方案
| Product Specific Protocols | |
|---|---|
| IHC protocol for PPP1CB antibody 10140-2-AP | Download protocol |
| IP protocol for PPP1CB antibody 10140-2-AP | Download protocol |
| WB protocol for PPP1CB antibody 10140-2-AP | Download protocol |
| Standard Protocols | |
|---|---|
| Click here to view our Standard Protocols |
发表文章
| Species | Application | Title |
|---|---|---|
Am J Physiol Cell Physiol PP1γ functionally augments the alternative splicing of CaMKIIδ through interacting with ASF. | ||
Melanoma Res Differential expression patterns of capping protein, protein phosphatase 1, and casein kinase 1 may serve as diagnostic markers for malignant melanoma. | ||
Clin Exp Pharmacol Physiol Rescue of cardiac failing and remodeling by inhibition of PP1γ is associated with suppression of the ASF-mediated splicing of CaMKIIδ | ||
Comput Struct Biotechnol J Alternative polyadenylation regulates the translation of metabolic and inflammation-related proteins in adipose tissue of gestational diabetes mellitus | ||
Adv Sci (Weinh) Histones Methyltransferase NSD3 Inhibits Lung Adenocarcinoma Glycolysis Through Interacting with PPP1CB to Decrease STAT3 Signaling Pathway | ||
J Exp Clin Cancer Res Non-canonical activation of MAPK signaling by the lncRNA ASH1L-AS1-encoded microprotein APPLE through inhibition of PP1/PP2A-mediated ERK1/2 dephosphorylation in hepatocellular carcinoma |